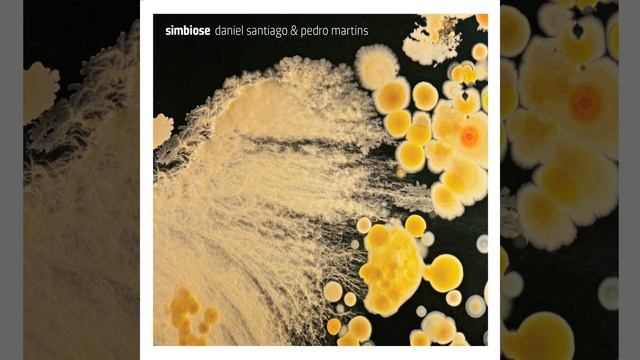
Refletindo смотреть онлайн

Автор / Канал: Wildlife Watcher Страница 13

Метис кабан со шкурой бараном

НЕОБЫЧНЫЙ ПРИБОРНЫЙ ПОИСК!

Taste of Odisha | ଉଷୁନା ଭାତ ଚକୁଳି | Usuna Bhata Chakuli - Odia Recipes

free fire new incubator elite moco malayalam BROWN FLICK

Short review of zealot s67, jbl charge 5, zealot s39. Which one do you think has a better sound 🎧✅

Танцы на море, сбежать от рутины!

Життя яке воно є, без прикрас

lego cobra kai (4 season)

ESP Eclipse CTM-I 4-Knob Matte Black Custom Transition Model 2011 Guitar - Up Close Video Review

Песня кукушка пела 1 раз не обсуждайте строго

One Drawing 4 Styles (pt.3) art #satisfying #shorts #posca

HAPPY BIRTHDAY KAIA! TURING 7 and OPENING SURPRISE TOYS! The TOYTASTIC Sisters! FAMILY VLOG!

Juwel Primo 70L (2) - Tetra Min Crips
Refletindo

Sultanka

Neon City (Original, 2013)

|LIVE POGAdankowy z Danio!

Live @ Radio Intense 17.09.2013 - Katya Tsaryova

How Do You Do Line Dance (contra dance)

Акулы в Москвариуме

Is He The One? How To Meet And Attract Your Man? Exact Steps by Katya Go Coaching

усталар хизмати арзон нархларда!!! 31 Май 2023!!!

Cavani signs for Valencia on a free transfer The Uruguayan puts his feet on the bat stadium 🦇

получил маску кролика!удивительный момент в METEL
За каждым успешным каналом стоит личность, идея и сотни часов кропотливого труда. Если вы здесь, значит, автор «Wildlife Watcher» уже сумел зацепить ваше внимание своим уникальным стилем или подачей. А мы на RUVIDEO позаботились о том, чтобы вы могли изучить весь архив его работ в максимально комфортных условиях — без лишней суеты и преград.
Почему за работами канала «Wildlife Watcher» так интересно наблюдать? Всё просто: это честный контент, который находит отклик в сердцах зрителей. На нашем ресурсе вы можете смотреть онлайн все видео любимого автора бесплатно и в хорошем качестве. Нам важно, чтобы вы видели каждую деталь и слышали каждый нюанс, поэтому мы используем только стабильные плееры из открытых источников Rutube.
Следите за новинками канала, пересматривайте старые шедевры и открывайте для себя новые грани творчества «Wildlife Watcher». Мы постоянно обновляем ленту, чтобы у вас под рукой всегда были самые свежие выпуски. Никаких сложных регистраций — только вы и творчество, которое вдохновляет. Приятного вам путешествия по миру авторского контента на RUVIDEO!
Видео взято из открытых источников Rutube. Если вы правообладатель, обратитесь к первоисточнику.